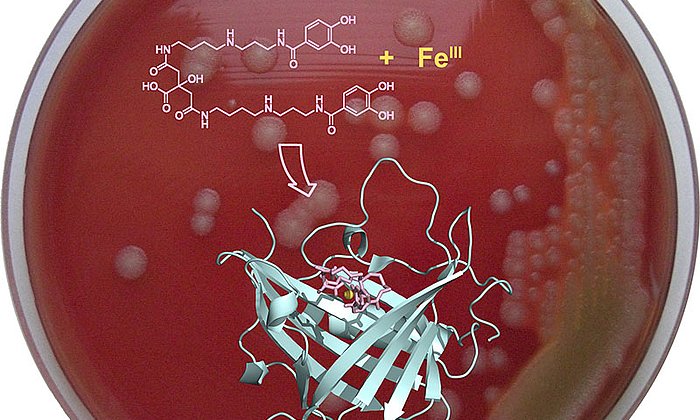
Scientists have developed an innovative strategy for preventing the anthrax bacterium from absorbing iron.

Artificial sugar-binding protein may inhibit cell growth
Blocking sugar structures on viruses and tumor cells

The laboratory directed by Arne Skerra, Professor of Biological Chemistry, has its focus on designing artificial binding proteins for therapeutic applications. The laboratory’s current research findings are paving the way for the development of new types of binding proteins for biological sugar structures, which play a significant role in cancer as well as infectious diseases.
Recognizing biological sugar structures
“The recognition of specific sugar molecules, or so-called carbohydrates, is of vital importance in many biological processes,” Prof. Skerra explains. Most cells carry a marker consisting of sugar chains which are attached to the outside of the cell membrane or to the membrane proteins, thus enabling the body to identify where these cells belong or whether certain cells are alien. Pathogens also have sugar structures of their own, or they can bind to these.
Proteins, which perform a wide range of functions within cells, generally have only low affinity to sugars. Thus, their molecular recognition poses a challenge. The reason: water molecules look similar to the sugar molecules, meaning that they are basically hidden in the aqueous environment of the cells. Prof. Skerra’s research group therefore set out to design an artificial binding protein with a peculiar chemical composition which makes it easier to bind to biological sugar structures.
A boric acid group implemented into a protein as amino acid
Amino acids are the building blocks of proteins. As a rule, nature only uses 20 amino acids in all living organisms. “Using the possibilities opened up by synthetic biology, we have employed an additional artificial amino acid,” reports researcher Carina A. Sommer.
“We have succeeded in incorporating a boric acid group, which exerts intrinsic affinity to sugar molecules, into the amino acid chain of a protein. In doing this, we have created an entirely new class of binding protein for sugar molecules,” Sommer explains. This artificial sugar-binding function is superior to natural binding proteins (so-called lectins) both in strength and with regard to possible sugar specificities.
“The sugar-binding activity of boric acid and its derivatives has been known for nearly a century,” says Prof. Skerra. “The chemical element boron is common on earth and has low toxicity, but so far has largely remained unexplored by organisms.”
“By using X-ray crystallography, we have succeeded in unraveling the crystal structure of a model complex of this artificial protein, which allowed us to validate our biomolecular concept,” explains scientist Dr. Andreas Eichinger.
The next step: towards medical application
Following approximately five years of fundamental scientific research, the findings from Prof. Skerra’s laboratory can now be applied to practical medical needs. Prof. Skerra points out: “Our results should not only be used to support the future development of new carbohydrate ligands in biological chemistry, but should also pave the way for creating high-affinity agents for controlling or blocking medically-relevant sugar structures on cell surfaces.”
Such a “blocking agent” could be used for conditions in which strong cell growth is evident or when pathogens are attaching themselves to cells, for example in oncology and virology. If we are successful in blocking the sugar-binding function and in slowing down the progress of a disease, this would give the patient’s immune system sufficient time to mobilize the body's natural defense.
Carina A. Sommer, Andreas Eichinger, and Arne Skerra (2020): A Tetrahedral Boronic Acid Diester Formed by an Unnatural Amino Acid in the Ligand Pocket of an Engineered Lipocalin. ChemBioChem 21:469-472. DOI: 10.1002/cbic.201900405
Images for journalists: https://mediatum.ub.tum.de/1540812
Technical University of Munich
Corporate Communications Center
- Dr. Katharina Baumeister-Krojer
- katharina.baumeister@tum.de
- 08161/ 71-5403
- presse@tum.de
- Teamwebsite
Contacts to this article:
Prof. Dr. Arne Skerra
Technical University of Munich
Chair of Biological Chemistry
Tel.: +49 (0)8161 71-4351
skerra@tum.de